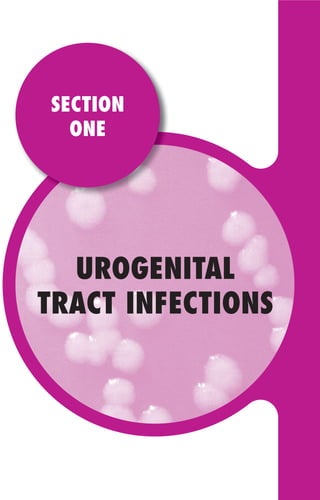
GENITOURINARY
TRACT INFECTIONS
SECTION
ONE
UROGENITAL
TRACT INFECTIONS
SECTION
ONE
SECTION
ONE
Gilligan_Sec1_025-062.indd 25 7/24/14 11:43 AM
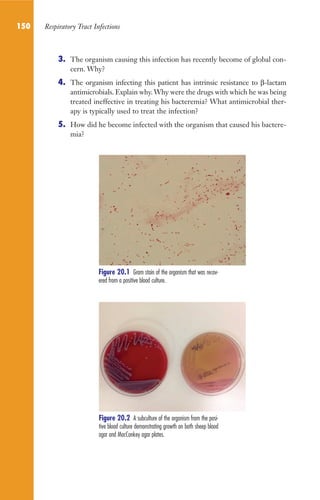
150 Respiratory Tract Infections
3. The organism causing this infection has recently become of global con-
cern. Why?
4. The organism infecting this patient has intrinsic resistance to β-lactam
antimicrobials. Explain why.Why were the drugs with which he was being
treated ineffective in treating his bacteremia? What antimicrobial ther-
apy is typically used to treat the infection?
5. How did he become infected with the organism that caused his bactere-
mia?
Figure 20.2 A subculture of the organism from the posi-
tive blood culture demonstrating growth on both sheep blood
agar and MacConkey agar plates.
Figure 20.1 Gram stain of the organism that was recov-
ered from a positive blood culture.
Gilligan_Sec2_063-156.indd 150 7/24/14 11:43 AM
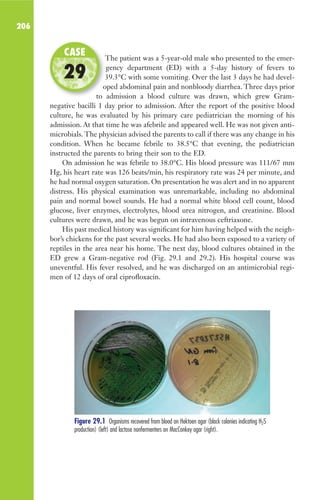
206
The patient was a 5-year-old male who presented to the emer-
gency department (ED) with a 5-day history of fevers to
39.3°C with some vomiting. Over the last 3 days he had devel-
oped abdominal pain and nonbloody diarrhea. Three days prior
to admission a blood culture was drawn, which grew Gram-
negative bacilli 1 day prior to admission. After the report of the positive blood
culture, he was evaluated by his primary care pediatrician the morning of his
admission. At that time he was afebrile and appeared well. He was not given anti-
microbials. The physician advised the parents to call if there was any change in his
condition. When he became febrile to 38.5°C that evening, the pediatrician
instructed the parents to bring their son to the ED.
On admission he was febrile to 38.0°C. His blood pressure was 111/67 mm
Hg, his heart rate was 126 beats/min, his respiratory rate was 24 per minute, and
he had normal oxygen saturation. On presentation he was alert and in no apparent
distress. His physical examination was unremarkable, including no abdominal
pain and normal bowel sounds. He had a normal white blood cell count, blood
glucose, liver enzymes, electrolytes, blood urea nitrogen, and creatinine. Blood
cultures were drawn, and he was begun on intravenous ceftriaxone.
His past medical history was significant for him having helped with the neigh-
bor’s chickens for the past several weeks. He had also been exposed to a variety of
reptiles in the area near his home. The next day, blood cultures obtained in the
ED grew a Gram-negative rod (Fig. 29.1 and 29.2). His hospital course was
uneventful. His fever resolved, and he was discharged on an antimicrobial regi-
men of 12 days of oral ciprofloxacin.
The patient was a 5-year-old male who presented to the emer-
39.3°C with some vomiting. Over the last 3 days he had devel-
oped abdominal pain and nonbloody diarrhea. Three days prior
to admission a blood culture was drawn, which grew Gram-
CASE
29
Figure 29.1 Organisms recovered from blood on Hektoen agar (black colonies indicating H2S
production) (left) and lactose nonfermenters on MacConkey agar (right).
Gilligan_Sec3_157-254.indd 206 7/24/14 11:44 AM
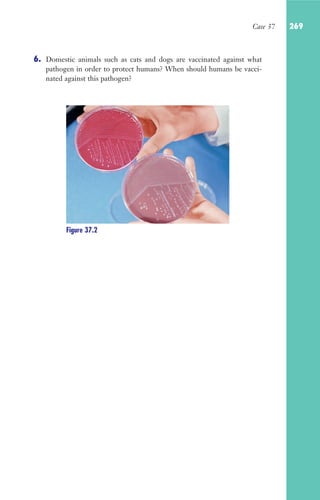
Case 37 269
Figure 37.2
6. Domestic animals such as cats and dogs are vaccinated against what
pathogen in order to protect humans? When should humans be vacci-
nated against this pathogen?
Gilligan_Sec4_255-306.indd 269 7/24/14 11:44 AM

This document provides a table of normal laboratory values for various hematologic and biochemical parameters in adults, newborns, and children. It includes reference ranges for complete blood counts, blood gases, liver and kidney function tests, and other biochemical parameters. It also provides European equivalents for some values and notes that values may be lower for infants and children.

![Table of Normal Valuesa
WBC 4,000–12,000/μl [4–12 × 109
/liter]
Neutrophils 2,000–7,500/μl [2–7.5 × 109
/liter]
Eosinophils 40–400/μl [0.04–0.40 × 109
/liter]
Platelets 150,000–400,000/μl [150–400 × 109
/liter]
pO2 85–100 mmHg [11.3–13.3 kPa]
CD4 count 430–1,185/μl (adults) [Same]
Male Female
Hemoglobin 13.4–17.4 g/dl 12.3–15.7 g/dl
[Haemoglobin] [Same] [Same]
Hematocrit 40–54% 38–47%
[Haematocrit] [0.4–0.54 liter/liter] [0.38-0.47 liter/liter]
Erythrocyte sedimentation rate 0–20 mm/h 0-30 mm/h
[ESR is usually calculated by age: male (ESR = 0.5 × age); female (ESR = 0.5 × {age +
10}); alternatively, the American values given here usually apply.]
Male Female Newborn Age 1
ALT 10–53 U/liter 7–30 U/liter
AST 11–40 U/liter 9–26 U/liter 35–140 U/liter 20–60 U/liter
Creatinine 0.8–1.5 mg/dl 0.6–1.2 mg/dl Lower for children
[Creatinine (male and female) = 70–150 μmol/liter]
Creatinine kinase 61–200 U/liter 30–125 U/liter
Albumin 3.5–5.0 g/dl [35–50 g/liter]
Serum glucose (fasting) 65–110 mg/dl [<3.6–6.1 mmol/liter]
Alkaline phosphatase 39–117 U/liter [Same]
Total bilirubin 0–1.2 mg/dl [0–20 μmol/liter]
Lactate dehydrogenase 108–215 U/liter [Same]
CSF glucose 50–75 mg/dl [2.8–4.2 mmol/liter, or 2/3 blood glucose]
CSF protein 15–45 mg/dl [0.15–0.45 g/liter]
CSF total nucleated cells 0–3/μl [Same]
Body temperature 37°C
Heart rate 60–100/min; higher for infants and children
Respiratory rate 9–18/min; higher for infants and children
Blood pressure 90–150/50–90; lower for infants and children
a
Values in brackets indicate European equivalents. If no value is given, the American value is used.
croInfDis7-22.indd 2
Gilligan_FM_i-xiv.indd 2 7/30/14 9:42 AM](https://image.slidesharecdn.com/casosclinicosmicrobiologa-221218135759-46848451/85/CASOS-CLINICOS_MICROBIOLOGIA-pdf-2-320.jpg)

![29
The patient was a 19-year-old female with a history of a urinary
tract infection (UTI) 4 months prior to admission for which
she was treated with oral ampicillin without complications. Five
days prior to this admission she began to note nausea without
vomiting. One day later she developed left flank pain, fevers, and
chills and noted increased urinary frequency. She noted foul-smelling urine on the
day prior to admission. She presented with a temperature of 38.8°C, and physical
examination showed left costovertebral angle tenderness. Urinalysis of a clean-
catch urine sample was notable for 50 white blood cells per high-power field, 3
to 10 red blood cells per high-power field, and 3+ bacteria. Urine culture was
subsequently positive for 105
CFU of an organism per ml (seen growing on cul-
ture in Fig. 1.1 [sheep blood agar] and Fig. 1.2 [MacConkey agar]). Note that the
organism is beta-hemolytic.
1. What do the urinalysis findings indicate? Explain your answer.
2. Why were the numbers of organisms in her urine quantitated on cul-
ture? How would you interpret the culture results in this case?
3. Which Gram-negative rods are lactose fermenters? Which one is also
often beta-hemolytic?
4. This bacterium was resistant to ampicillin. What in this patient’s history
might explain this observation? Multidrug-resistant strains of this
organism are beginning to be seen as an important cause of UTI.
Describe the mechanism of resistance that these organisms most likely
will have.
5. UTIs are more frequent in women than men. Why?
6. Did this woman have cystitis or pyelonephritis? Why is it important to
differentiate between the two?
7. Briefly explain the evolution of the organism causing this infection in
terms of its ability to infect the urinary tract. What virulence factors
have been shown to play a pathogenic role in this infection?
The patient was a 19-year-old female with a history of a urinary
she was treated with oral ampicillin without complications. Five
days prior to this admission she began to note nausea without
vomiting. One day later she developed left flank pain, fevers, and
CASE
1
Figure 1.1 Figure 1.2
Gilligan_Sec1_025-062.indd 29 7/24/14 11:43 AM](https://image.slidesharecdn.com/casosclinicosmicrobiologa-221218135759-46848451/85/CASOS-CLINICOS_MICROBIOLOGIA-pdf-45-320.jpg)



























































































![Case 14 121
tions with these organisms. Unfortunately, this prophylaxis is ineffective against Fusarium,
Trichophyton, and the zygomycetes. Although all of these agents are still much less frequent
causes of invasive disease in neutropenic HSCT recipients, they may cause invasive disease
despite the use of antifungal prophylaxis and cause devastating invasive disease with a high
mortality rate.
7. Because they are almost never positive in patients with invasive aspergillosis, blood
cultures have little diagnostic value. In patients with invasive aspergillosis, the organism
has a predilection for invading endothelial cells and, as a result, is rarely detected in the
bloodstream. Fungal agents that are recovered from blood cultures include Candida spp.,
Cryptococcus neoformans, Trichosporon, and the dimorphic fungi Histoplasma capsulatum and
Blastomyces dermatitidis. Fusarium is the only mold that is recovered with any degree of
frequency from routine broth blood cultures. See case 68 for additional details.
REFERENCES
1. Dagenais TR, Keller NP. 2009. Pathogenesis of Aspergillus fumigatus in invasive aspergil-
losis. Clin Microbiol Rev 22:447–465.
2. De Pauw B, Walsh TJ, Donnelly JP, Stevens DA, Edwards JE, Calandra T, Pappas PG,
Maertens J, Lortholary O, Kauffman CA, Denning DW, Patterson TF, Maschmeyer
G, Bille J, Dismukes WE, Herbrecht R, Hope WW, Kibbler CC, Kullberg BJ, Marr
KA, Muñoz P, Odds FC, Perfect JR, Restrepo A, Ruhnke M, Segal BH, Sobel JD,
Sorrell TC, Viscoli C, Wingard JR, Zaoutis T, Bennett JE; European Organization
for Research and Treatment of Cancer/Invasive Fungal Infections Cooperative
Group; National Institute of Allergy and Infectious Diseases Mycoses Study Group
(EORTC/MSG) Consensus Group. 2008. Revised definitions of invasive fungal disease
form the European Organization for Research and Treatment of Cancer/Invasive Fungal
Infections Cooperative Group and the National Institute of Allergy and Infectious Diseases
Mycoses Study Group (EORTC/MSG) Consensus Group. Clin Infect Dis 46:1813–1821.
3. Graf K, Khani SM, Ott E, Mattner F, Gastmeier P, Sohr D, Ziesing S, Chaberny IF.
2011. Five-years surveillance of invasive aspergillosis in a university hospital. BMC Infect
Dis 11:163. doi: 10.1186/1471-2334-11-163.
4. Heng SC, Morrissey O, Chen SC, Thursky K, Manser RL, Nation RL, Kong DC,
Slavin M. 2013. Utility of bronchoalveolar lavage fluid galactomannan alone or in combi-
nation with PCR for the diagnosis of invasive aspergillosis in adult hematology patients:
a systematic review and meta-analysis. Crit Rev Microbiol [Epub ahead of print] doi:
10.3109/1040841X.2013.804033.
5. Walsh TJ, Anaissie EJ, Denning DW, Herbrecht R, Kontoyiannis DP, Marr KA,
Morrison VA, Segal BH, Steinbach WJ, Stevens DA, van Burik JA, Wingard JR,
Patterson TF; Infectious Diseases Society of America. 2008. Treatment of aspergillosis:
clinical practice guidelines of the Infectious Diseases Society of America. Clin Infect Dis
46:327–360.
Gilligan_Sec2_063-156.indd 121 7/24/14 11:43 AM](https://image.slidesharecdn.com/casosclinicosmicrobiologa-221218135759-46848451/85/CASOS-CLINICOS_MICROBIOLOGIA-pdf-137-320.jpg)










![132
This 26-year-old man presented for evaluation of a neck mass
and a right axillary mass. The patient, who came to the United
States from Vietnam 6½ years ago, noted a right axillary mass 1
month prior to admission. The mass gradually increased in size.
Approximately 3 weeks prior to admission he noted a midline neck
mass. These masses were incised and drained twice. Samples of purulent material
were sent for routine bacterial culture at an outside hospital. The patient had lost
3 kg (ca. 7 lb) in the 2 months prior to admission but denied fever. Travel history
was notable for his having lived in Arizona for 6 years prior to moving to Boston.
On examination, he was afebrile. An erythematous, fluctuant, nontender mass
(8 cm by 6 cm) was present in the midline of the neck (Fig. 17.1; computed
tomography [CT] scan in Fig. 17.2). The right axilla demonstrated incision sites
that were draining and were tender to palpation. He had no adenopathy else-
where. His PPD (purified protein derivative) skin test was reactive, and his chest
X ray was notable for apical scarring in the right lung.
1. Because of the reactive PPD and apical scarring seen on the patient’s
chest X ray, the clinical suspicion of cervical tuberculosis (scrofula) was
high, and the patient was begun on a four-drug anti-tuberculous regi-
men. Other than tuberculosis, what is in the differential diagnosis of the
neck and axillary mass?
2. Several days after the neck mass was drained of several milliliters of
purulent material for culture, a mold was found to grow on the blood
agar plates in the routine bacteriology section of the microbiology lab-
oratory. The laboratory technologist did not notice the presence of the
mold and opened the plates to examine them for bacteria. Why is this of
concern?
This 26-year-old man presented for evaluation of a neck mass
States from Vietnam 6½ years ago, noted a right axillary mass 1
month prior to admission. The mass gradually increased in size.
Approximately 3 weeks prior to admission he noted a midline neck
CASE
17
Figure 17.1 Figure 17.2
Gilligan_Sec2_063-156.indd 132 7/24/14 11:43 AM](https://image.slidesharecdn.com/casosclinicosmicrobiologa-221218135759-46848451/85/CASOS-CLINICOS_MICROBIOLOGIA-pdf-148-320.jpg)

![Case 30 215
CASE DISCUSSION
1. This patient had one colony of a sorbitol-negative organism (see the
arrow pointing to the colorless colony surrounded by pink [sorbitol-
fermenting] colonies on sorbitol MacConkey agar in Fig. 30.1). Isolates that
fail to ferment sorbitol are unusual among Escherichia coli. One of the most common
sorbitol-negative serotypes of E. coli is O157:H7, an organism associated with bloody
diarrhea. Subsequent serotyping of this sorbitol-negative colony confirmed it as E. coli
O157:H7. An alternative culture approach is to use chromogenic agar, which can detect
sorbitol-negative E. coli. E. coli O157:H7 is also referred to as Shiga toxin-producing E. coli
(STEC) because of its ability to produce Shiga toxin, the major virulence factor in the
development of enterohemorrhagic colitis (inflammation of colon with bloody diarrhea).
Other serotypes of E. coli can produce Shiga toxin and thus cause enterohemorrhagic
colitis (see answer 2 for further details), but O157:H7 appears to be the most common
cause of this illness in the Northern Hemisphere, although perhaps not in the Southern
Hemisphere.
2. All STEC strains produce Shiga toxin, and most strains produce intimin. There are
two forms of Shiga toxin, Stx1 and Stx2. STEC strains can produce both or either toxin.
Biochemically the two toxins are both AB5 toxins with the B subunits binding to a specific
glycosphingolipid receptor, GB3, found on both epithelial and renal endothelial cells. The
A subunit is taken into the endoplasmic reticulum, where it inhibits protein synthesis at
the ribosomal level, causes apoptosis, and promotes expression of proinflammatory cyto-
kines. In animal models, these toxins have been shown to induce the pathophysiology
associated with STEC. Stx1 and Stx2 are distinct toxins both sequentially and immuno-
logically. Stx2 represents a family of toxins with seven subtypes. Stx2 is associated with the
most severe manifestation of STEC infection, hemolytic-uremic syndrome (HUS) (see
answer 3 for more details). Two subtypes, Stx2a and Stx2c, either alone or in combination,
are most frequently associated with HUS.
A second virulence factor frequently found in STEC is an outer membrane protein,
intimin. E. coli strains that express intimin use a type 3 secretion system to inject a receptor,
translocation intimin receptor (Tir), into the host cell, to which intimin binds. Intimin-
producing E. coli strains form a specific lesion referred to as an attaching-and-effacing
lesion. This lesion is characterized by the formation of a pedestal on the surface of the
epithelial cell on which the intimin-containing bacterium sits.
Multiple serotypes of E. coli are able to cause enterohemorrhagic colitis because the
genes that code for Shiga toxin are carried on a phage that can be transferred to a number
of different serotypes of E. coli. More than 100 different E. coli serotypes causing Shiga
toxin-induced disease have been found in humans.
fermenting] colonies on sorbitol MacConkey agar in Fig. 30.1). Isolates that
CASE
30
Gilligan_Sec3_157-254.indd 215 7/24/14 11:44 AM](https://image.slidesharecdn.com/casosclinicosmicrobiologa-221218135759-46848451/85/CASOS-CLINICOS_MICROBIOLOGIA-pdf-231-320.jpg)

![Case 40 289
5. The most important human pathogen among the mycobacteria is Mycobacterium
tuberculosis. Because it is adapted to growing in humans, it grows readily at 35 to 37°C.
As a result, human specimens are cultured at this temperature to ensure the recovery of
the most pathogenic of the mycobacteria. However, environmental mycobacteria (also
referred to as nontuberculous mycobacteria) make up the bulk of the mycobacterial
species to which humans are exposed. Many of these organisms, which include M. mari-
num, grow better at 30°C. In fact, M. marinum grows poorly, if at all, at 35 to 37°C.
Since environmental mycobacteria are much more likely to cause skin, soft tissue, and
joint infections, it is recommended that these specimens be cultured at both 30°C and
35 to 37°C.
6. A common strategy for screening patients to detect infection with M. tuberculosis is
to do a skin test in which 5 tuberculin units are injected intradermally into the volar
surface of the forearm. If the patient is infected with M. tuberculosis (tuberculosis [TB]),
an area of induration will appear after 48 to 72 hours. This induration is due to a
delayed-type hypersensitivity reaction to purified protein derivative present in the skin
test material. Induration of 5, 10, or 15 mm is considered positive depending on the
patient population tested, with 5 mm being used as a cutoff for immunocompromised
patients, 10 mm for high-risk individuals such as those with documented exposures, and
15 mm for individuals with a low index of suspicion. It should be remembered that 90%
of patients who are infected with M. tuberculosis are latently infected and will not have
clinical symptoms.
Of patients with M. marinum infections, more than half will have a false-positive TB
skin test. If these patients are tested, it may result in further testing such as a chest radio-
graph or even the initiation of M. tuberculosis therapy. M. tuberculosis therapy in patients
with M. marinum infections is problematic because the mainstay of M. tuberculosis therapy
is isoniazid, an agent with known liver toxicity and no activity against M. marinum. Given
the high rate of false-positive TB skin tests in this clinical setting and the low pretest
probability of this being M. tuberculosis, TB skin testing really has no role in the manage-
ment of this patient.
REFERENCES
1. Aubry A, Chosidow O, Caumes E, Robert J, Cambau E. 2002. Sixty-three cases of
Mycobacterium marinum infection: clinical features, treatment, and antibiotic susceptibility
of causative isolates. Arch Intern Med 162:1746–1752.
2. Chan ES, Cronstein BN. 2010. Methotrexate—how does it really work? Nat Rev
Rheumatol 6:175–178.
3. Lewis FM, Marsh BJ, von Reyn CF. 2003. Fish tank exposure and cutaneous infections
due to Mycobacterium marinum: tuberculin skin testing, treatment, and prevention. Clin
Infect Dis 37:390–397.
Gilligan_Sec4_255-306.indd 289 7/24/14 11:44 AM](https://image.slidesharecdn.com/casosclinicosmicrobiologa-221218135759-46848451/85/CASOS-CLINICOS_MICROBIOLOGIA-pdf-305-320.jpg)






![296 Skin and Soft Tissue Infections
CASE DISCUSSION
1. Ticks are vectors for Borrelia burgdorferi (the agent of Lyme disease),
other Borrelia species (which cause relapsing fever), Francisella tularensis (the
agent of tularemia), Babesia microti (the agent of babesiosis), Rickettsia rickettsii
(the etiologic agent of Rocky Mountain spotted fever [RMSF]), Ehrlichia chaffeensis (caus-
ing human monocytic ehrlichiosis), Anaplasma phagocytophilum (the agent of human gran-
ulocytic anaplasmosis), Colorado tick fever virus, Powassan virus, and other rickettsiae
and viruses not found in the United States. R. rickettsii is endemic in the state of North
Carolina, with Oklahoma or North Carolina reporting the largest number of RMSF cases
on a yearly basis. Ninety percent of cases occur between the months of April and
September, a period when adult ticks, the stage that spreads the organism, are most
actively feeding. For R. rickettsii to be transmitted to humans, the infected tick must be
attached for a minimum of 6 to 10 hours, and more than 24 hours may be required for
transmission to occur. The incubation time after tick exposure ranges from 2 to 14 days,
with a median of 7 days.The patient’s development of symptoms 8 days after tick exposure
is consistent with R. rickettsii infection. The tick removed from this child was Dermacentor
variabilis, the common dog tick. This tick is known to transmit R. rickettsii, F. tularensis,
E. chaffeensis, and A. phagocytophilum. The other tick that commonly acts as a vector for
R. rickettsii in North America is Dermacentor andersoni, the Rocky Mountain wood tick.
Although rare, other modes of acquisition of RMSF infections include needlesticks, blood
transfusions, or lab accidents that occur when working with the organism.
2. The most likely etiology of the patient’s infection is R. rickettsii, which causes RMSF.
The physical finding of a skin rash, in the presence of fever, myalgias, vomiting, and diar-
rhea, with a history of a tick bite in a geographically compatible area, is highly suggestive
of RMSF. Hyponatremia (low Na+
level) is commonly seen in RMSF, as are low platelet
counts and increased coagulation times, both of which can be manifestations of dissemi-
nated intravascular coagulation (DIC), an often fatal complication of this infection.
This case took place in North Carolina. The failure of her pediatrician to recognize
that she had RMSF most certainly contributed to her demise. Patients with a skin rash
(seen in 90% of patients with RMSF), fever, and tick exposure in North Carolina have
RMSF until proven otherwise. Mortality with RMSF is ~1 to 3% with timely, appropriate
antimicrobial therapy with doxycycline but may reach as high as 25% in untreated indi-
viduals.
In the United States, where RMSF epidemiology has been most closely scrutinized,
African-Americans are the population in which the disease has the greatest severity. The
reasons for this appear to be 2-fold. First, in dark-skinned individuals, the rash, which is
the key diagnostic feature of this infection, may be difficult to appreciate. This may delay
the diagnosis and appropriate treatment, which can have grave clinical consequences,
most importantly, increased mortality. Second, African-Americans often have poorer
agent of tularemia),
CASE
42
Gilligan_Sec4_255-306.indd 296 7/24/14 11:44 AM](https://image.slidesharecdn.com/casosclinicosmicrobiologa-221218135759-46848451/85/CASOS-CLINICOS_MICROBIOLOGIA-pdf-312-320.jpg)




































































































































































































































































































